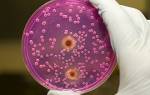

Причины возникновения
Причиной развития заболевания является герпетический вирус, известный как вирус Эпштейна — Барр. Он предпочитает поражать лимфоидно-ретикулярную ткань, в частности, лимфатические узлы и селезенку, где проявляет свою разрушительную активность. Попадая в организм, эти вирусы способны также наносить вред внутренним органам.
Получение инфекции от вредоносных микроорганизмов может происходить различными способами:
- Распространение через контакт и быт. Чаще всего дети заражаются, если не соблюдают правила личной гигиены. Использование посуды других людей, особенно если она не была должным образом вымыта и промыта, может привести к заражению. Остатки слюны больного человека могут сохраняться на посуде в течение длительного времени. Нарушение правил гигиены и употребление пищи из посуды инфицированного человека может привести к заражению.
- Передача через воздух и капли. Этот способ передачи вирусов от больного ребенка к здоровому довольно распространен. Вирусы — это мельчайшие микроорганизмы, которые легко попадают в организм через воздух. Обычно инфицирование происходит во время разговора или чихания.
- Через внутривенное введение. В педиатрии этот способ заражения встречается очень редко, он более характерен для взрослых. Инфицирование в этом случае возможно во время проведения различных хирургических операций или при переливании крови. Нарушение техники безопасности медицинских процедур приводит к заражению.
- Через плаценту. В этом случае источником инфекции для младенца является мама. Ребенок заражается от нее еще внутриутробно. Во время беременности инфицированная мама может передать вирусы, способные проникать через плаценту, своему младенцу. Если у беременной женщины есть различные аномалии и патологии, связанные с плацентарной недостаточностью, то риск заражения младенца инфекционным мононуклеозом возрастает в несколько раз.
Уменьшение защитных сил организма способствует развитию этого заболевания. Обычно это происходит после частых простудных заболеваний или под воздействием сильного психоэмоционального стресса.
Иммунная система также снижает свою активность при сильном переохлаждении. Организм ребенка становится особенно уязвимым для проникновения различных патогенных микроорганизмов, включая вирус простого герпеса.
У детей старше года обычно проявляются клинические симптомы этого заболевания. У грудных младенцев такая инфекционная патология встречается крайне редко из-за наличия специфических пассивных иммуноглобулинов, которые защищают их от различных инфекций, включая опасные герпесвирусы. Младенцы получают эти защитные иммуноглобулины от матери через материнское молоко во время кормления грудью.
Многие родители интересуются, возможно ли, чтобы их ребенок заболел инфекционным мононуклеозом несколько раз за свою жизнь. Мнения ученых и врачей по этому поводу расходятся. Некоторые эксперты утверждают, что после преодоления болезни у ребенка формируется прочный иммунитет. Однако их оппоненты утверждают, что герпесвирус невозможно полностью вылечить. Микробы остаются в организме ребенка и могут пребывать там на протяжении всей жизни, и при ослаблении иммунитета заболевание может вернуться снова.
Как долго длится инкубационный период этого заболевания? Обычно он длится от 4 дней до одного месяца. В это время ребенок обычно чувствует себя хорошо. Некоторые внимательные родители могут заметить незначительные изменения в поведении малыша. В течение инкубационного периода у ребенка может быть небольшая медлительность и рассеянность, иногда нарушается сон. Однако эти признаки проявляются настолько слабо, что не вызывают у родителей никаких беспокойств.
Лечение мононуклеоза
Для взрослых, которые проходят лечение мононуклеоза, особенно в домашних условиях, важно использовать одноразовые или персональные столовые приборы и посуду, а также избегать близких контактов с членами семьи и близкими.
Для лечения мононуклеоза необходимо использовать комбинированный подход. Выбор лекарств зависит от того, насколько выражены различные симптомы этого заболевания.
- Всем пациентам будут предложены препараты против вирусов, такие, как Гропринозин, Вальтрекс и Ацикловир, Вальтрекс.
- Препараты без стероидов, которые имеют противовоспалительное действие, используются для снижения температуры и уменьшения воспаления в очагах заболевания. Для этой цели подходят Парацетамол, Ибупрофен, Нимесулид (Найз).
Нимесулид (Найз) является одним из наиболее эффективных препаратов для снижения температуры при мононуклеозе.
Обратите внимание! При данном заболевании не только нежелательно принимать ацетилсалициловую кислоту, абсолютно запрещено!
- Для уменьшения отека миндалин, задней части горла и селезенки могут быть назначены препараты из группы антигистаминных средств: Цитеризин, Лоратадин, супрастин.
- Иногда пациентам рекомендуется применение специфического иммуноглобулина против вируса Эпштейн-Барр.
- При необходимости (для предотвращения осложнений или их лечения) в отдельных случаях могут быть назначены препараты из группы глюкокортикоидов (Преднизолон), а также антибиотики (за исключением препаратов из группы Ампициллиновых).
- Если пациент испытывает ощущение сухости и болезненности в горле, ему рекомендуется местное лечение – обработка слизистой при помощи Хлоргексидина, Фурациллина или Гевалекса.
При мононуклеозе особенно важную роль играет специальная диета. Лечащий врач обычно рекомендует придерживаться диеты стола № 5, которая исключает потребление животных жиров, копченых, острых, жареных и маринованных блюд. Также важно отказаться от употребления сладкого, спиртного и кофе.
Исключительно важными окажутся куриной бульон, йогурты и кефир, предпочтительно натуральные, с закваской в основе. Кроме того, для пациентов будут полезны не кислые соки или компоты.
Для ускорения выздоровления от мононуклеоза рекомендуется правильное питание, включающее в себя питательные легкие бульоны.
Для ускорения восстановления здоровья пациентов, а также для смягчения проявлений заболевания, рекомендуется применение народных методов в дополнение к медикаментозному лечению.
Например:
- использование настойки Эхинацеи способно укрепить иммунитет;
- применение отвара аира или имбиря помогает предотвратить развитие вторичной бактериальной инфекции и уменьшить болевые ощущения в горле;
- бузина и одуванчик быстро облегчат головную боль и значительно укрепят ослабленный болезнью организм;
- И самое главное, в природе существует удивительное лекарственное растение, обладающее выраженными противовирусными свойствами, которое можно использовать в качестве этиотропной терапии!
Это растение называется Астрагал, и из него можно приготовить:
— Настой: растертый корень, взятый в объеме 1 столовой ложки, заливают 200 мл только что закипевшей воды и выдерживают в термосе 1-2 часа, затем охлаждают, процеживают и употребляют по ½ стакана 3-4 раза в день.
— Начинка: измельченный корень в объеме 6 грамм заливают 200 миллилитрами воды, нагревают до кипения на водяной бане в течение 15 минут, затем настаивают 1-2 часа в теплом месте. Принимают по той же схеме, что и настой.
Во время восстановительного периода и в течение продолжительного времени после него, людям необходимы отдых, правильное питание, достаточный сон и прием витаминов (например, Супрадин, Витрум, Компливит).
Рекомендации доктора Комаровского
Родители должны уведомить дошкольное учреждение или школу о том, что их ребенок заболел инфекционным мононуклеозом. Однако не требуется вводить карантин. Просто необходимо уделять больше внимания влажной уборке помещений.
Восстановление после перенесенного инфекционного мононуклеоза — это длительный процесс, во время которого иммунитет сильно ослаблен. В течение ближайшего года (иногда полугода) лечащий педиатр отменяет все календарные прививки у таких детей. Длительное пребывание в тесных детских коллективах не рекомендуется. Поездка на море для «поднятия» иммунитета не является хорошей идеей из-за тяжелой акклиматизации после перенесенного вирусного заболевания. В течение года не рекомендуется длительное пребывание на солнце и посещение секций с интенсивной физической нагрузкой.
Для поддержания организма в процессе восстановления необходимо принимать витаминные комплексы, соответствующие возрасту.
После выздоровления ребенка необходимо регулярно обследовать у врача. Вирус обладает способностью вызывать онкологические заболевания, поэтому важно следить за состоянием здоровья. Если в течение длительного времени после болезни в анализах крови ребенка продолжают обнаруживать измененные мононуклеарные клетки, необходимо обратиться к гематологу для дальнейшего наблюдения и консультации.
После преодоления вируса, который вызывает инфекционный мононуклеоз, организм вырабатывает стойкий иммунитет, который сопровождает человека на протяжении всей жизни. Возможность повторного заболевания этим недугом исключена. Исключение составляют лишь люди, инфицированные ВИЧ, у которых могут возникать множественные острые эпизоды заболевания.
Лечение инфекционного мононуклеоза у детей

Как можно вылечить инфекционный мононуклеоз? На данный момент не существует фармпрепаратов, способных полностью устранить возбудителей этого заболевания. Лечение направлено на облегчение симптомов и предотвращение серьезных последствий. Известный доктор Комаровский утверждает, что при легкой форме болезни не требуется специальная терапия. Если состояние ребенка нормальное, достаточно обильного питья и соблюдения постельного режима. Поскольку заразный период для других детей продолжается, посещение детских садов и школ не рекомендуется. Также следует отменить прогулки до полного выздоровления. Госпитализация необходима в случае тяжелого течения болезни с высокой температурой, частой рвотой, угрозой задыхания и нарушением функций внутренних органов.
Терапия при заболевании средней тяжести
Лечение инфекции Эпштейна-Барр направлено на:
- Использование препаратов против вирусов и лекарств для снижения температуры (для детей рекомендуется «Парацетамол» или «Ибупрофен»);
- Применение местных антисептических средств;
- Неспецифическую иммуномодулирующую терапию с применением препаратов «Виферон», «Анаферон», «Циклоферон», «Эргоферон» и других;
- Использование препаратов против аллергии и антигистаминных средств;
- Витаминотерапию;
- При выявлении поражения печени — применение желчегонных препаратов и гепатопротекторов.
Для предотвращения присоединения бактериологической инфекции при сильном воспалении глотки врачи выписывают антибиотические препараты. Вместе с антибиотиками обычно принимают пробиотики, такие как «Наринэ», «Аципол», «Примадофилус». В случае тяжелой гипертоксической формы заболевания с риском удушья врач может порекомендовать применение препарата «Преднизолон». Диета для детей при инфекционном мононуклеозе предполагает употребление жидкой пищи, богатой ценными элементами, с низким содержанием жиров для облегчения работы печени. При значительном поражении печени и селезенки рекомендуется придерживаться диеты стола №5. Еще одним важным советом будет поддержание оптимальной влажности воздуха в комнате ребенка.
Прогноз и последствия

При встрече с вирусом, вызывающим железистую лихорадку, организм формирует прочный иммунитет. Если ребенок переболел инфекционным мононуклеозом, то повторное заражение исключено. Исключение составляют пациенты с ВИЧ. Факт перенесенного заболевания всегда отражается в медицинской истории. Инфекционный мононуклеоз во время беременности относится к заразным заболеваниям, которые представляют опасность для будущей мамы и ее ребенка. Железистая лихорадка может привести к осложнениям, таким как выкидыш или развитие патологий у младенца. Это заболевание негативно влияет на иммунитет женщины, делая ее более уязвимой для заражения другими, еще более опасными инфекциями после инфекционного мононуклеоза.
Дети, переболевшие болезнью, должны регулярно проходить обследование у инфекциониста в течение полугода.
Осложнения при инфекционном мононуклеозе встречаются редко и возникают, когда вторичная вирулентная микрофлора активизируется на фоне ослабленного иммунитета. Эти осложнения могут проявиться в виде воспаления легких, печени, среднего уха, верхнечелюстных пазух и других органов. В случае выраженной отечности гортани и затруднений с дыханием рекомендуется применение трахеостомии и подключение пациента к аппарату вентиляции легких. Одной из основных опасностей мононуклеоза является разрыв селезенки, который может произойти из-за снижения количества тромбоцитов и излишнего растяжения капсулы этого органа. В этом случае необходима немедленная операция, так как без специализированной помощи это состояние может привести к смерти. При выявлении разрыва селезенки требуется срочное удаление селезенки. Если возникают сильные болевые ощущения в верхней левой части живота, учащается сердцебиение, затруднено дыхание, необходимо вызывать скорую помощь. Если кто-то из членов семьи заразился мононуклеозом, риск заражения других членов семьи увеличивается. На данный момент не существует специальных методов профилактики этого заболевания. Единственными возможными мерами профилактики являются укрепление иммунной системы и избегание потенциально опасных ситуаций, например, посещение многолюдных мест в период эпидемий.
Какая назначается терапия для взрослых
Улучшение состояния больных взрослых основывается на смягчении проявлений заболевания и предотвращении возникновения вторичных инфекций.
Следует отметить, что лечение должен назначать только квалифицированный специалист. Таким образом, для лечения взрослых могут быть использованы следующие средства: . Препараты, стимулирующие иммунитет и борющиеся с вирусами: «Виферон», «Анаферон», «Арбидол», «Имудон» и другие.
Препараты для снижения температуры, такие как «Ибупрофен»;
Антигистаминные препараты, такие как «Зодак», «Супрастин», «Диазолин» и другие, используемые для лечения аллергических и воспалительных процессов;
Антисептические средства, такие как «Мирамистин», «Хлорофиллипт», «Фурацилин», применяемые для лечения горла;
Лечение отеков миндалин с использованием «Преднизалона», «Дексаметазона» может быть назначено в случае угрозы удушья;
Сосудосуживающие препараты для носа, такие как «Нафтизин», «Санорин» и другие;
Для поддержания функций печени врач может рекомендовать «Эссенциале Форте», «Антраль»;
Лечение также может включать витаминотерапию, включая витамины группы В, С и Р;
Лечение ангины может включать прием антибиотиков, таких как «Сумамед», «Цефалоспорин», а также пробиотиков, таких как «Линекс», «Хилак Форте».
- Препараты, стимулирующие иммунитет и борющиеся с вирусами: «Виферон», «Анаферон», «Арбидол», «Имудон» и другие;
- Препарат «Ибупрофен», снижающий температуру;
- Препараты от аллергии и воспаления, такие как «Зодак», «Супрастин», «Диазолин» и другие антигистамины;
- Антисептические средства, используемые для лечения горла: «Мирамистин», «Хлорофиллипт», «Фурацилин»;
- Препараты для снятия отеков миндалин, такие как «Преднизалон», «Дексаметазон», применяемые в случае угрозы задушевому состоянию;
- Препараты для сужения сосудов в носу – «Нафтизин», «Санорин» и другие;
- Для поддержания работы печени врач может назначить препараты «Эссенциале Форте», «Антраль»;
- Лечение включает витаминотерапию, включая витамины группы В, С и Р;
- Лечение ангины может включать прием антибиотиков, таких как «Сумамед», «Цефалоспорин», а также пробиотиков, таких как «Линекс», «Хилак Форте»;
Важно помнить, что помимо применения лекарств для борьбы с инфекционным мононуклеозом, необходимо оказать поддержку организму.
Для достижения этой цели необходимо придерживаться специального питания и обеспечить себе полноценный отдых. Питание включает в себя следующие аспекты:
- Рекомендуется употреблять больше здоровой пищи. Рацион при мононуклеозе включает в себя цельные злаки, крупы, рыбу, яйца, фрукты.
- При данном заболевании у взрослых диета полностью исключает быструю пищу (фаст-фуды), газированные напитки, кофе, алкоголь.
- Питание следует употреблять маленькими порциями и часто, чтобы не перегружать организм, который уже ослаблен. При мононуклеозе у взрослых рекомендуется употреблять пищу 6 раз в день.
При проведении полноценной терапии и соблюдении диеты, вероятность возникновения осложнений инфекционного мононуклеоза у взрослых крайне невелика.
В период ремиссии хронического мононуклеоза симптомы могут проявляться по-разному у разных людей: у кого-то селезенка немного увеличена, у других – лимфоузлы и так далее. Однако в большинстве случаев пациенты испытывают головные и мышечные боли, слабость, сонливость, и развивается так называемый «синдром постоянной усталости».
Иногда возникают такие осложнения и последствия, как недостаточность работы печени, разрыв селезенки, гемолитическая анемия, воспаление миокарда.
Причины
Инфекционный мононуклеоз у взрослых возникает из-за вируса Эпштейна-Барр, который заражает поверхностные эпителии слизистой оболочки полости рта и горла через органы дыхания. При близком контакте с инфицированной слизистой оболочкой B-лимфоциты также подвергаются вирусному заражению, после чего вирус начинает активно размножаться в них. Это приводит к образованию атипичных мононуклеаров, которые распространяются по крови до носоглоточных и нёбных миндалин, а также до печени, селезёнки и лимфатических узлов.
Все перечисленные органы полностью состоят из иммунной, другими словами – лимфоидной, ткани. Используя их, вирус также начинает активно размножаться и постоянно стимулировать их значительный рост.
У заболевшего внезапно появляется высокая температура, возникают острые боли в области горла. Перехватить опасный вирус Эпштейна-Барр возможно только от зараженного человека. Даже на первый взгляд полностью здоровый человек легко может стать источником вирусного заболевания при наличии инфекции в его слюне. Такой человек называется вирусоносителем.
Для взрослого человека существует несколько причин заражения вирусом Эпштейна-Барр, включая:
- инфекционный вирус, содержащийся в слюне, может передаваться воздушно-капельным путем при кашле или чихании;
- поцелуй – это значительный способ заражения при контакте;
- признак бытового заражения – общее использование различными предметами быта (посудой, полотенцем, зубной щеткой, женщины – помадой и другими предметами);
- мононуклеоз у взрослых может присутствовать как в слюне, так и в сперме, поэтому вирус может передаваться при половом контакте;
- при процедуре переливания инфицированной крови мононуклеоз может скрывать риск заражения и легко передаваться через кровь здоровому человеку;
- осуществление пересадки внутренних органов от вирусоносителя.
В некоторых случаях мононуклеоз у взрослых и детей может быть ошибочно диагностирован как острое респираторное вирусное заболевание. В таких ситуациях вирус может находиться в спящем состоянии или болезнь может протекать в мягкой форме. Поэтому у 90% населения могут отсутствовать явные симптомы заболевания.
Мононуклеоз может проявляться в виде систематических случаев, которые часто возникают в семьях и коллективах, где произошла вспышка этого заболевания, а также среди людей, инфицированных ВИЧ. Заболеваемость отмечается круглый год, но наибольший рост заболеваемости приходится на весенний и осенний периоды. Основными «целями» мононуклеоза являются люди в возрасте от двадцати до тридцати лет. Симптомы и лечение мононуклеоза у взрослых отличаются от других заболеваний, имея свои особенности.
Инфекционный мононуклеоз, симптомы
Симптомы мононуклеоза у детей
До настоящего момента не существует специальных методов профилактики против заражения описанным вирусом. Поэтому, если ребенок был в контакте с зараженным, родители должны внимательно наблюдать за его состоянием в течение следующих трех месяцев. Если в течение этого времени не появятся признаки заболевания, можно считать, что заражение не произошло, либо иммунитет подавил вирус, и заражение прошло бессимптомно. Однако, если появятся признаки общей интоксикации, такие как повышенная температура, озноб, сыпь, слабость, увеличение лимфоузлов, то необходимо немедленно обратиться к педиатру или инфекционисту (в случае вопроса о том, какой врач лечит мононуклеоз).
Симптомы вируса Эпштейна-Барра у детей на ранней стадии заболевания включают общее недомогание, катаральные проявления и слабость. Затем появляется першение в горле, небольшая температура, покраснение и отечность слизистой ротоглотки, заложенность носа, увеличение миндалин. В некоторых случаях возникает острая форма развития инфекции, когда симптомы появляются внезапно, а их выраженность быстро усиливается (сонливость, лихорадка до 39 градусов в течение нескольких дней, озноб, усиленное потоотделение, слабость, боли в мышцах и горле, головная боль). Затем наступает период основных клинических проявлений инфекционного мононуклеоза, при котором наблюдается:
- увеличение объема печени и селезенки;
- высыпания на коже;
- зернистость и покраснение окологлоточного кольца;
- общее отравление организма;
- увеличение лимфатических узлов.
Высыпания при мононуклеозе, изображения
Кожная сыпь при мононуклеозе обычно возникает в начальной стадии заболевания, одновременно с увеличением лимфатических узлов и повышением температуры тела, и располагается на руках, лице, ногах, спине и животе в форме мелких красноватых пятен. Этот симптом не вызывает зуда и не требует специального лечения, так как исчезает сам по себе по мере выздоровления пациента. Если у человека, который принимает антибиотики, начинает зудеть сыпь, это может указывать на развитие аллергической реакции, поскольку при мононуклеозе кожная сыпь не вызывает зуда.
Самым важным признаком описываемого заболевания является воспаление лимфатического узла, что приводит к его увеличению. Часто на миндалинах появляются отдельные участки светлого налета, которые легко удаляются. Также увеличиваются окружные лимфатические узлы, особенно шейные. При повороте головы они становятся заметными. Ощупывание лимфатических узлов вызывает чувствительность, но не вызывает боли. Реже увеличиваются брюшные лимфатические узлы, и при их давлении на регионарные нервы может возникнуть симптоматика «острого живота». Это может привести к неправильной диагностике и проведению хирургического вмешательства.
Симптомы мононуклеоза у взрослых
Встречаемость вирусного мононуклеоза у лиц старше 25-30 лет крайне редка, поскольку данная группа обычно обладает сформированным иммунитетом к возбудителю этого заболевания. У взрослых симптомы вируса Эпштейна-Барра, если они все-таки появляются, не отличаются от симптомов у детей.
Гепатоспленомегалия у детей и взрослых
Как было отмечено ранее, характерной особенностью описываемого заболевания является увеличение печени и селезенки. Органы печени и селезенки очень чувствительны к вирусу, поэтому увеличение их размеров у ребенка и взрослого наблюдается уже в начальные дни заболевания. Общие причины увеличения печени и селезенки у детей и взрослых включают различные вирусные инфекции, онкологические заболевания, а также заболевания крови и системную красную волчанку. Поэтому в данной ситуации необходимо провести комплексное обследование.
Признаки заболевшей селезенки у человека:
- увеличение объема органа, которое можно обнаружить при ощупывании и УЗИ;
- болезненные ощущения, чувство тяжести и дискомфорт в левых областях живота.
Селезенка может увеличиться из-за заболевания до такой степени, что сам орган может разорвать свою оболочку. В течение первых 15-30 дней размеры печени и селезенки продолжают увеличиваться, но когда температура тела возвращается к норме, их размеры снова становятся обычными.
Признаки разрыва селезенки у взрослых и детей, выявленные при изучении медицинских записей пациентов:
- затемнение перед глазами;
- чувство тошноты и потребность в рвоте;
- мелькание света перед глазами;
- ощущение слабости;
- приступы головокружения;
- нарастающая боль в животе расплывчатого характера.
Чем лечить селезенку?
При увеличении размеров селезенки рекомендуется ограничить физическую активность и придерживаться постельного режима. В случае выявления разрыва этого органа требуется немедленное хирургическое вмешательство для его удаления.
Причины появления инфекционного мононуклеоза у детей
Наиболее уязвимыми перед этим заболеванием являются дети в возрасте до 10 лет. Вирус Эпштейна-Барра чаще всего циркулирует в закрытых коллективах, таких как детские сады и школы, где он передается воздушно-капельным путем. При попадании в открытую среду вирус быстро погибает, поэтому заражение происходит только при близких контактах. Вирус мононуклеоза обнаруживается в слюне инфицированного человека, поэтому он может передаваться при чихании, кашле, поцелуях и использовании общей посуды.
Мононуклеоз, вызванный инфекцией, у детей: изображение.
Важно отметить, что данное заболевание чаще диагностируется у мальчиков, чем у девочек, в два раза чаще. У некоторых пациентов вирусный мононуклеоз протекает бессимптомно, но при этом они являются носителями вируса и могут представлять потенциальную опасность для здоровья окружающих. Выявить их можно только при помощи специального анализа на мононуклеоз.
Вирусные частицы проникают в организм через дыхательные пути. Время, прошедшее с момента заражения до появления симптомов, обычно составляет от 5 до 15 дней. Однако, согласно информации, полученной из интернет-форумов и отдельных пациентов, инкубационный период может растянуться до полутора месяцев (причины этого явления пока неизвестны). Мононуклеоз – довольно распространенное заболевание: более половины детей заражаются вирусом Эпштейна-Барра до достижения возраста пяти лет, однако у большинства детей симптомы проходят незаметно, и заболевание не проявляется. Среди взрослого населения уровень инфицированности варьируется от 85 до 90%, и лишь у некоторых проявляются симптомы, позволяющие поставить диагноз инфекционный мононуклеоз. Возможно возникновение следующих особых форм заболевания:
- Необычный мононуклеоз проявляется у детей и взрослых более ярко, чем обычно, например, температура может подниматься до 39,5 градусов, а иногда заболевание протекает без повышения температуры. При этой форме лечения диета играет важную роль, так как необычный мононуклеоз может вызывать тяжелые осложнения и последствия у детей.
- Хронический мононуклеоз, описанный в соответствующем разделе, рассматривается как последствие ухудшения работы иммунной системы больного.
У родителей часто возникают вопросы о том, как долго длится повышенная температура при данной инфекции. Продолжительность этого симптома может значительно различаться в зависимости от индивидуальных особенностей: от нескольких дней до полутора месяцев. При этом решение о том, нужно ли принимать антибиотики при гипертермии, должен принимать лечащий врач.
Также часто возникает вопрос: нужно ли принимать препарат Ацикловир? Ацикловир включен во многие официально рекомендуемые схемы лечения, однако последние исследования показывают, что такая терапия не оказывает влияния на ход заболевания и не улучшает состояние пациента.
Методы лечения и признаки заболевания у детей (варианты лечения мононуклеоза и способы его лечения у детей) также подробно изложены в передаче Е.О. Комаровского «Инфекционный мононуклеоз».
Видеозапись от доктора Комаровского:
Классификация патологии
В зависимости от степени выраженности характерных признаков, инфекционный мононуклеоз может проявляться:
- обычно: характерно полное и подробное описание заболевания;
- без симптомов: отсутствие любых клинических признаков болезни, диагноз устанавливается только с помощью специальных лабораторных анализов;
- с нерезкой симптоматикой: основные проявления заболевания выражены слабо или напоминают респираторное заболевание;
- с основным поражением внутренних органов (висцеральная форма): в клинических проявлениях на первом месте стоят изменения в нервной, сердечно-сосудистой, мочевыделительной, эндокринной и других системах или органах.
В зависимости от продолжительности клинических проявлений, болезнь может проявляться острым, длительным или хроническим образом. Острый инфекционный мононуклеоз диагностируется с момента заболевания и до 3 месяцев, от 3 до 6 месяцев – проявление болезни в длительной форме, хронический – наличие симптомов патологии более 6 месяцев.
Прогноз и последствия мононуклеоза
Людям, которые перенесли вирусный мононуклеоз, обычно прогнозируют благоприятное восстановление.
Предсказание возможного развития инфекционного мононуклеоза
Важно отметить, что ключевым условием предотвращения осложнений и негативных последствий является своевременное выявление лейкозов и регулярное мониторинг изменений в крови
Кроме того, крайне важно следить за состоянием здоровья пациентов до тех пор, пока они полностью не поправятся. В процессе научных исследований было установлено:
- если температура тела превышает 37,5 градусов, она может сохраняться в течение нескольких недель;
- признаки ангины и боли в горле могут продолжаться от 1 до 2 недель;
- состояние лимфатических узлов восстанавливается примерно за 4 недели после проявления заболевания;
- жалобы на сонливость, усталость и слабость могут сохраняться еще в течение 6 месяцев.
Люди, которые перенесли болезнь, в том числе и дети, должны регулярно проходить обследование в поликлинике в течение полугода-года, включая обязательное проведение периодических анализов крови.
Осложнения встречаются редко в целом. Самые частые последствия включают гепатит, желтушность кожи и изменение цвета мочи. Самое серьезное осложнение мононуклеоза – разрыв оболочки селезенки, который происходит из-за низкого уровня тромбоцитов и растяжения капсулы органа, требующий срочной операции. Другие осложнения могут включать развитие вторичной стрептококковой или стафилококковой инфекции, менингоэнцефалита, асфиксии, тяжелых форм гепатита и интерстициальной двусторонней инфильтрации легких.
В настоящее время не существует эффективных и специфических методов профилактики данного расстройства.
Симптомы у детей
Если у ребенка крепкий иммунитет, возбудитель инфекции, попав в организм, может находиться в нем бессимптомно длительное время. Инкубационный период составляет 21 день, но при ослабленной защите инфекция проявляется уже через 5 суток. Симптомы мононуклеоза похожи на проявления других заболеваний, врачи-педиатры должны провести дифференциальную диагностику их от таких патологий:
- заболевание лимфатических узлов;
- инфекция печени;
- острое респираторное заболевание;
- эпидемический паротит;
- острая форма лейкоза;
- инфекционное заболевание с поражением слизистых оболочек;
- острое воспаление гланд;
- вирус иммунодефицита человека.
Первым признаком развития инфекционного заболевания является увеличение лимфатических узлов. Особенно сильно поражаются шейные, затылочные и подчелюстные лимфоузлы, сопровождающиеся значительной болезненностью. При дальнейшем развитии инфекции происходит увеличение паховых, брюшных и подмышечных лимфатических узлов. Затем возникает воспаление миндалин и отечность тканей в области носа. У детей наблюдаются следующие признаки мононуклеоза:
- неприятные ощущения в горле при глотании;
- появление белого налета на миндалинах;
- неприятный запах изо рта, который вызывает дискомфорт;
- затруднение дыхания через нос;
- храп во время сна;
- насморк, вызывающий неприятные ощущения;
- появление кашля.
При заражении вирусом Эпштейна-Барра происходит отравление организма продуктами его жизнедеятельности. При этом температура поднимается до 39 градусов, возникают лихорадка, озноб, ощущение слабости в костях и мышцах. Среди признаков мононуклеоза выделяются:
- розовая сыпь, не вызывающая зуда, которая исчезает сама по себе;
- увеличение размеров селезенки и печени;
- изменение цвета мочи;
- боли в голове;
- сильную усталость;
- потерю аппетита;
- ощущение слабости;
- вялость.
При заражении увеличивается вероятность возникновения респираторных заболеваний. Также отмечается нарушение функционирования сердца – появление шумов и учащение сердечного ритма. При этом заболевании наблюдаются следующие признаки:
- прогрессирование ангины и бронхита;
- изменение характеристик крови;
- воздействие вируса простого герпеса на губы;
- отечность век и лица;
- проявление головокружения;
- эпизоды мигрени;
- проблемы с засыпанием;
- симптомы усталости.

Хронический мононуклеоз
Опасность заключается в том, что задержка диагностики инфекции и отсутствие своевременного лечения могут привести к переходу заболевания в хроническую форму. У детей с мононуклеозом в этом случае температура остается на нормальном уровне, но присутствуют следующие симптомы:
- постоянное увеличение размера лимфоузлов;
- быстрая утомляемость истощение;
- сонливость и повышенная сонливость;
- снижение активности и энергии;
- нарушение стула – запор или понос;
- боли в области живота;
- тошнота и ощущение тошноты;
- слабость и ощущение слабости;
- рвота и ощущение тошноты с последующим рвотным рефлексом.
Признаки хронической формы инфекции часто напоминают острую, но проявляются менее ярко. Увеличение размеров селезенки и печени встречается нечасто. Это заболевание представляет опасность для детей из-за возможного развития следующих осложнений:
- синдром фагоцитоза – разложение организмом своих собственных кровеносных клеток;
- поражение центральной нервной системы, головного мозга;
- изменения в функционировании сердца;
- проблемы с коагуляцией крови;
- нарушение выразительности лица;
- возникновение приступов мигрени;
- психические расстройства;
- недостаток крови.
Острый
Чаще всего инфекция проявляется в острой форме, которая длится до двух месяцев. Возникает лимфаденопатия – поражение лимфоузлов, сопровождающееся увеличением и болезненностью. Отек слизистых оболочек полости рта вызывает затруднения в дыхании и гиперемию горла. Ребенок сообщает о появлении:
- общей усталости и слабости организма;
- болей в горле, особенно при глотании пищи;
- заложенности носа и затрудненного дыхания через нос;
- наличия насморка и излишнего выделения слизи;
- сильного озноба и дрожи от холода;
- отсутствия желания к питанию и потери аппетита.
Острая форма мононуклеоза проявляется увеличением температуры, появлением тошноты, ощущением усталости в мышцах и суставах, а также лихорадочным состоянием. У детей при развитии инфекции могут возникать следующие симптомы:
- гепатомегалия – увеличение размера печени;
- мелкая сыпь на области груди, спины, лица, шеи;
- белый налет на миндалинах, небе, языке, задней части глотки;
- спленомегалия – увеличение размера селезенки;
- чувствительность к яркому свету;
- отечность век.
Частые вопросы
Чем характеризуется мононуклеоз у детей?
Мононуклеоз у детей, вызванный вирусом Эпштейна-Барра, характеризуется высокой температурой, увеличением лимфоузлов, болью в горле и усталостью.
Как передается мононуклеоз у детей?
Мононуклеоз у детей передается через слюну, кашель, поцелуи и общие предметы, загрязненные слюной.
Полезные советы
СОВЕТ №1
Объясните родителям, что мононуклеоз вызван вирусом Эпштейна-Барра и передается через слюну, поэтому важно следить за гигиеной и избегать обмена посудой, полотенцами и предметами личной гигиены с больным ребенком.
СОВЕТ №2
Рекомендуйте обратиться к врачу при появлении симптомов, таких как высокая температура, увеличение лимфоузлов, боль в горле и усталость, чтобы получить точное диагностирование и назначение лечения.